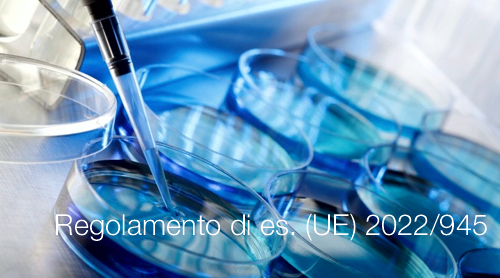
Regolamento di es  UE 2022 945

Regolamento di esecuzione (UE) 2022/945
| ID 16889 | | Visite: 2169 | Regolamento DMD Vitro | Permalink: https://www.certifico.com/id/16889 |
Regolamento di esecuzione (UE) 2022/945
Regolamento di esecuzione (UE) 2022/945 della Commissione del 17 giugno 2022 recante modalità di applicazione del regolamento (UE) 2017/746 del Parlamento europeo e del Consiglio per quanto riguarda i diritti che possono essere riscossi dai laboratori di riferimento dell’UE nel settore dei dispositivi medico-diagnostici in vitro
GU L 164/20 del 20.6.2022
Entrata in vigore: 10.07.2022
_______
Articolo 1 Struttura dei diritti
1. Possono essere coperte dai diritti riscossi dai laboratori di riferimento dell’UE le seguenti categorie di spesa:
a) spese per il personale, comprese le spese di viaggio e le spese di alloggio e di soggiorno correlate;
b) spese per le attrezzature, ove le attrezzature non siano fornite dal fabbricante del dispositivo da sottoporre a test;
c) spese per i materiali di consumo, i campioni di prova e i materiali di riferimento;
d) spese di spedizione dei campioni;
e) spese di traduzione;
f) spese generali di funzionamento del laboratorio.
2. Fatto salvo il paragrafo 1, se il laboratorio di riferimento dell’UE ha stipulato un contratto con un altro laboratorio a norma dell’articolo 7, paragrafo 1 o 2, del regolamento di esecuzione (UE) 2022/944 della Commissione , il diritto riscosso dal laboratorio di riferimento dell’UE può coprire l’importo versato a tale laboratorio conformemente a tale contratto per lo svolgimento del compito richiesto.
Articolo 2 Livello dei diritti
1. I diritti riscossi dai laboratori di riferimento dell’UE sono non discriminatori, equi, ragionevoli e proporzionati ai servizi prestati.
2. I laboratori di riferimento dell’UE stabiliscono l’importo dei diritti sulla base delle spese sostenute.
Se il calcolo delle spese sostenute è irragionevolmente gravoso per una particolare categoria di spesa di cui all’articolo 1, paragrafo 1, lettere da a) a e), i laboratori di riferimento dell’UE possono stimare le spese sostenute sulla base delle spese medie per tale categoria.
L’importo del diritto a copertura delle spese di cui all’articolo 1, paragrafo 1, lettera f), è determinato calcolando una percentuale delle spese di cui all’articolo 1, paragrafo 1, lettere da a) a e), combinate e non supera il 7 % di tali spese.
Articolo 3 Regole per il calcolo dei diritti
1. I laboratori di riferimento dell’UE stabiliscono le regole in base alle quali calcolano i diritti per lo svolgimento dei compiti richiesti, comprese le regole per la stima delle spese sostenute sulla base delle spese medie, e le pubblicano sui loro siti web.
2. I laboratori di riferimento dell’UE riesaminano le regole di cui al paragrafo 1 almeno ogni due anni e, se necessario, le adeguano.
[...]
Collegati